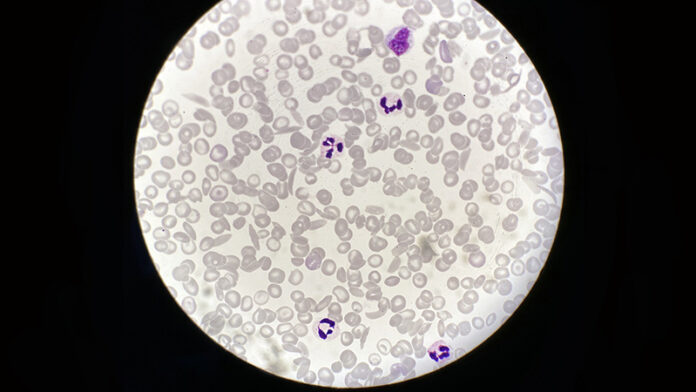

[ad_1]
The FDA placed a clinical hold yesterday on two gene therapy trials for sickle cell disease (SCD) after one participant developed acute myeloid leukemia (AML) and another developed myelodysplastic syndrome (MDS). The sponsoring company, bluebird bio, suspended the trials last week upon learning of the cases.
The company has also put the brakes on a treatment for beta thalassemia already approved in the European Union and the United Kingdom, betibeglogene autotemcel (Zynteglo). The treatment hasn’t been associated with problems but uses the same gene delivery vector, a lentivirus, as that used in the SCD trials.
Overall, the company has enrolled 47 SCD patients and 63 with beta thalassemia in trials.
The gene therapy “space” is one with spectacular successes — for a form of retinal blindness and spinal muscular atrophy — rising against a backdrop of recent setbacks and failures — for Duchenne muscular dystrophy, lipoprotein lipase deficiency, and myotubular myopathy.
Table of Contents
A Lentiviral Vector
The retooled lentivirus used in the SCD trials, LentiGlobin, delivers a beta globin gene with one amino acid replacement to hematopoietic stem cells outside the patient’s body. The modified cells are then infused back into the patient. The gene therapy reshapes red blood cells, enabling them to circulate through narrow blood vessels without sickling and adhering into painful logjams.
What is worrisome is that in the patient who died from AML, who received the gene therapy more than 5 years ago, the cancer cells contained the vector. Those test results aren’t yet available for the participant who has MDS.
The finding raises suspicion that the gene therapy had a role in the cancer, but is only correlative.
Lentiviral vectors have a good track record, but the two cases evoke memories of two decades ago. In 2001, five boys being treated for an inherited immunodeficiency (SCID-X1) with a gamma retroviral vector developed leukemia and one died. Those viruses inserted into an oncogene. Happening 2 years after the death of 18-year-old Jesse Gelsinger in another gene therapy trial, the SCID trial had a chilling effect on the field.
Since then, lentiviral vectors have been reinvented to be “self-inactivating,” minimizing the risk for inserting willy-nilly into a genome. “Lentiviral vectors have been expressly designed to avoid insertional oncogenesis, based on prior experience with the gamma retroviruses. We don’t have evidence that the vector is causative, but our studies will shed some light on whether that’s true in these cases,” said bluebird bio chief scientific officer Philip Gregory, D.Phil, on a conference call February 16.
Lentiviral vectors have been successful as the backbone of CAR-T therapy, which directs modified T cells to certain blood cancers. “Among the hundreds to thousands of patients treated with CAR-T cell therapy, lentivirus vector hasn’t been associated with any malignancies,” said bluebird’s chief medical officer, Dave Davidson, MD.
Jeanne Loring, PhD, director of the Center for Regenerative Medicine at Scripps Research, agrees. “Gene therapy is having some extreme highs and lows these days. Most studies use [adeno-associated viral (AAV)] vectors, which don’t integrate into the genome. But some people have antibodies to AAV vectors, and AAV is diluted out when cells divide. That’s why lentivirus, which integrates into the genome, is used for blood stem cells and T cells in CAR-T therapy.”
Pinpointing Causality
At bluebird bio, investigation into the possible “genetic gymnastics” of the lentivirus vector is focusing on where it integrates into the genome — whether it harpoons an oncogene like the gamma retroviral vectors, or affects genome stability, Gregory explained. To be causative, the affected gene must be a “driver” of the cancer, and not just a “passenger,” he added.
Another suspect is busulfan, a drug used to “condition” the recipient’s bone marrow, making room for modified stem cells. “It’s possible that busulfan is the main problem, as it is a carcinogen unto itself,” said Paul Knoepfler, PhD, a stem cell researcher at the University of California, Davis.
Nick Leschly, chief of bluebird, pointed out the importance of clinical context in implicating the vector. Because SCD itself stresses the bone marrow, patients already face an increased risk of developing blood cancer, he said. “Now layer on other risks of the gene therapy. It’s challenging because we’re dealing with patients who have life expectancy in the mid 40s.” Previous treatments, such the antisickling drug hydroxyurea, may also contribute to patient vulnerability, he added.
A Patient’s View
SCD affects more than 100,000 people in the United States, and about 20 million globally. Charles Hough is one of them. He can attest to the severity of the disease as well as the promise of gene therapy
Hough was diagnosed at age 2, and endured the profound fatigue, pain crises, and even coma characteristic of severe cases. He cites his “rebirth” as September 25, 2018, when he received his first modified stem cells at the National Institutes of Health. Hough told his story a year ago in a webinar for the National Organization for Rare Disorders. Medscape Medical News caught up with him in light of the clinical trial hold.
Although the preparative regimens for the gene therapy were tough, his sickle cell symptoms vanished after gene therapy. Even hearing about the current hold on the clinical trial, Hough doesn’t regret his participation.
“I had a lot of friends who passed because of the complications from sickle cell. I was always worried that I wouldn’t live to see the next day. Now I don’t have that stress hanging over my head and I feel like I can live a normal life. Becoming sickle-cell-free was my dream.”
For more news, follow Medscape on Facebook, Twitter, Instagram, and YouTube.
[ad_2]
Source link